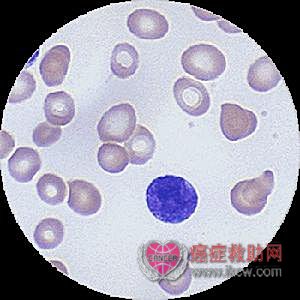

白血病的病理
作者:匿名
来源:癌症救助网
时间:2011-04-12 02:41:27
主要表现有白血病细胞的增生与浸润。非特异性病变则为出血及组织营养不良和坏死、继发感染等。白血病细胞的增生和浸润主要发生在骨髓及其他造血组织中,也可出现在全身其它组织中,致使正常的红系细胞、巨核系细胞显著减少。骨髓中可因某些白血病细胞增生明显活跃或极度活跃,而呈灰红色或黄绿色。淋巴组织也可被白血病细胞浸润,后期则淋巴结肿大。
主要表现有白血病细胞的增生与浸润。非特异性病变则为出血及组织营养不良和坏死、继发感染等。白血病细胞的增生和浸润主要发生在骨髓及其他造血组织中,也可出现在全身其它组织中,致使正常的红系细胞、巨核系细胞显著减少。骨髓中可因某些白血病细胞增生明显活跃或极度活跃,而呈灰红色或黄绿色。淋巴组织也可被白血病细胞浸润,后期则淋巴结肿大。有50%~80%白血病死者有明显中枢神经系统白血病改变。常见者为血管内白细胞瘀滞、血管周围白细胞增生。其它最常发生白血病浸润的脏器是肾、肺、心脏及胸腺、睾丸等。
通过以上可以看出,白血病浸润组织脏器比较集中而且严重,破坏组织能力较大。白血病在疾病过程中,大多伴有不同程度的出血,可发生在任何部位,但多见于造血组织、皮肤粘膜、心包膜、脾、胃及中枢神经等。其出血常发生在有白血病细胞浸润的基础上。由于白血病细胞浸润、出血,梗死及全身代谢障碍,局部或全部组织可有营养不良与萎缩,甚至坏死等。近年来由于大量化疗药物和抗生素的应用,其尸检病理变化有新的表现,白血病细胞崩解浸润消失,出现了纤维蛋白渗出,组织细胞吞噬,继而纤维化。骨髓可出现萎缩或纤维化,某些霉菌、原虫的感染增多,药物引起的病变增多。
现可知白血病是一种克隆性恶性病,恶性病变可发生在造血干细胞广泛范围内,累及的范围可以多少不一。恶性克隆的产生可能和多种因素有关,其中逆转录病毒感染原瘤基因激活是主要的,而放射线、化学毒物、药物(特别是烷化剂)以及遗传因素致染色体异常和免疫功能降低等促使了恶性克隆的产生和发展。某些造血系统疾病如骨髓增殖性疾病、骨髓增生异常综合征、阵发性睡眠性血红蛋白尿和淋巴瘤等最终也可以转化为白血病。
责任编辑: 秦曙东
癌症百问:
- 食管癌:食疗偏方
- 食道癌的食疗偏方
- 中医治疗食道癌5处方
- 食道癌:生芦根粥
- 食管癌:青礞石方(内服)
- 食管癌:民间偏方治疗法
- 食管癌:加味地黄汤(内服)
- 食管癌:健脾益气饮(内服)
- 食管癌:旋复代赭汤(内服)
- 食管癌:魔芋半夏汤(内服)
热点推荐:
Copyright © 2008-2021 www.ikcw.com 版权所有 癌症救助网 - 中国(慈善救助)癌症患者第一门户网站 未经授权请勿转载
互联网药品信息服务许可证 互联网医疗卫生信息服务许可证 京ICP备08101493号 京公网安备11010502022924
十年树木,百年树人。癌症救助网,坚持公益,坚持救助,做国际慈善癌症救助网络平台!

互联网药品信息服务许可证 互联网医疗卫生信息服务许可证 京ICP备08101493号 京公网安备11010502022924
十年树木,百年树人。癌症救助网,坚持公益,坚持救助,做国际慈善癌症救助网络平台!











